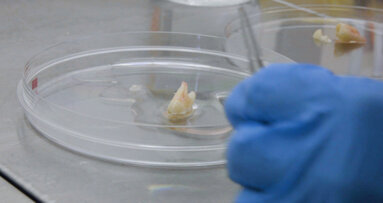
Des chercheurs étudient la possibilité de repousse de dents

BRESCIA, Italie : La péri-implantite est l‘une des pathologies multifactorielles fréquemment rencontrée à laquelle les chirurgiens-dentistes et hygiénistes dentaires sont confrontés. Selon un examen systématique d’épidémiologie publié dans le Journal of Clinical Parodontologie en 2015, 22 pour cent des patients ont été affectés par cette infection. Cependant, à ce jour, il n’y a pas de traitement standard ni essais randomisés dans la littérature qui comparent le traitement chirurgical et non chirurgical. Des chercheurs italiens ont maintenant mis au point un nouveau protocole non chirurgical qui présage des résultats prometteurs.
Une équipe de chercheurs, dirigée par le Dr Magda Mensi, professeur adjoint de parodontologie, chirurgie orale et implantologie à l'école dentaire et d'hygiène de l'Université de Brescia en Italie, a entrepris une étude pilote en 2013 pour déterminer si la combinaison poudre à faible abrasion - antibiotique topique-curetage pourrait être plus efficace contre la péri-implantite sévère que le débridement mécanique. Pour cela, le Dr Mensi a développé le protocole de traitement multiple anti-infectieux non-chirurgical (MAINST : Multiple Anti Infective Non Surgical Therapy ). Les chercheurs l’ont utilisé sur 15 patients avec implants dentaires souffrant de péri-implantite.
Le protocole MAINST implique l'utilisation d'un gel topique de doxycycline à 14% administré dans la phase de péri-implantite aiguë par une structure biodégradable à libération contrôlée, une séance de polissage ‘à l’aide d’une buse spéciale et de la poudre d'érythritol administrée sous gingivale, un curetage de la ligne de poche interne avec un dispositif piézocéramique avec des pointes revêtues de PEEK, et une deuxième application du gel de doxycycline.
Après 12 mois d'observation, le Dr Mensi et ses collègues ont constaté une diminution de 4 mm de réduction dans les profondeurs des poches de palpage, un gain de niveau de fixation de plus de 3,7 mm et, d'après un sondage, un taux de saignement de seulement 6,5 pour cent.Le taux de survie des implants à 12 mois était de 100%. Selon le Dr Mensi, les résultats obtenus étaient meilleurs que ceux des traitements conventionnels.De plus, au cours des quatre années qui ont suivi le début de l'étude, un seul patient a eu une réapparition de péri-implantite. Les chercheurs ont suggéré que cela était probablement dû au fait que la patiente a manqué plusieurs rendez-vous de contrôle et d'entretien, prenait des médicaments immunosuppresseurs, et souffrait d’une détérioration générale de sa santé.
Les patients ont subi des séances de maintenance trimestrielles et ont reçu des consignes particulières d'utilisation d’instruments de soins à domicile, tels que des brosses à dents soniques, des brossettes interdentaires et de la soie dentaire.« C'est très important.Les patients doivent être rendus attentifs à l'élimination de la plaque et du tartre, motivés à effectuer cet entretien à la maison, et se présenter à leurs suivis dentaires. S’ils reviennent seulement lors d’un problème, il sera trop tard , » a souligné le Dr Mensi.
Selon le Dr Mensi, les résultats de son étude indique que le protocole MAINST pourrait devenir la norme standardisée de traitement pour péri-implantite . «La seule chirurgie qui fonctionne vraiment pour la péri-implantite est la chirurgie régénérative et reconstructive, mais notre protocole peut être une meilleure alternative non chirurgicale. Nous allons mener une étude de contrôle randomisée pour valider cette hypothèse », a-t-elle expliqué.
L'étude, intitulée « Une nouvelle thérapie anti-infectieuse non-chirurgicale multiple dans le traitement de la péri-implantite: une série de cas» (A new multiple anti-infective non-surgical therapy in the treatment of peri-implantitis: A case series), a été publiée dans le numéro de décembre 2017 de la revue Minerva Stomatologica .
En Avril 2018 lors de l’International Dental Exhibition and Meeting (IDEM) à Singapour, le Dr Mensi présentera en détail les approches non chirurgicalesde la péri-implantite.Les professionnels dentaires peuvent obtenir plus d'informations sur l’IDEM sur www.idem-singapore.com.
Mots-clés:
Le titane est l’un des matériaux les plus utilisés pour les implants dentaires en raison de sa résistance mécanique, de sa biocompatibilité et de son...
La parodontite et la péri-implantite sont toutes deux des pathologies inflammatoires qui touchent le tissu gingival. En raison des dissemblances ...
HARLOW, Royaume-Uni / SAN FRANSISCO, États-Unis : À l’heure actuelle, les chercheurs ont pu répondre à de nombreuses questions concernant la Covid-19,...
VIENNE, Autriche / LYON, France : Lors de l’International Osteology Symposium Vienna 2026, qui s’est tenu le mois dernier à Vienne, en Autriche, le Pr ...
LONDRES, Royaume-Uni : Les lésions de furcation de grade III représentent l’un des défis les plus complexes en parodontologie, et les données ...
CAMBRIDGE, Massachusett., États-Unis : Des chercheurs du MIT ont mis au point un composite constitué principalement de nanocristaux de cellulose, de ...
BRUXELLES, Belgique : La Fédération européenne de parodontologie (EFP) a annoncé une nouvelle directive visant à aider les professionnels de la santé ...
CHICAGO, ÉTATS-UNIS : L'hydroxyapatite est un composant important des tissus durs. L'émail des dents, par exemple, présente la plus forte concentration ...
LONDRES, Angleterre : Le traitement du cancer de la tête et du cou est notoirement complexe, et peu de progrès ont été réalisés au cours des 20 ...
BERLIN, Allemagne : Pour certains animaux, la perte de dents n’est pas toujours un problème : les dents des requins et celles les crocodiles se ...
Webinaire en direct
mar. le 23 juin 2026
à 2h00 (CET) Paris
Webinaire en direct
mar. le 23 juin 2026
à 19h00 (CET) Paris
Webinaire en direct
mar. le 23 juin 2026
à 21h00 (CET) Paris
Webinaire en direct
mer. le 24 juin 2026
à 14h00 (CET) Paris
Webinaire en direct
mer. le 24 juin 2026
à 17h00 (CET) Paris
Webinaire en direct
mer. le 24 juin 2026
à 18h30 (CET) Paris
Dr. med. dent. Britta Hahn
Webinaire en direct
jeu. le 25 juin 2026
à 20h00 (CET) Paris
Dr. Hatem Algraffee, Cat Edney



 Autriche / Österreich
Autriche / Österreich
 Bosnie Herzégovine / Босна и Херцеговина
Bosnie Herzégovine / Босна и Херцеговина
 Bulgarie / България
Bulgarie / България
 Croatie / Hrvatska
Croatie / Hrvatska
 République tchèque et Slovaquie / Česká republika & Slovensko
République tchèque et Slovaquie / Česká republika & Slovensko
 France / France
France / France
 Allemagne / Deutschland
Allemagne / Deutschland
 Grèce / ΕΛΛΑΔΑ
Grèce / ΕΛΛΑΔΑ
 Hongrie / Hungary
Hongrie / Hungary
 Italie / Italia
Italie / Italia
 Pays-Bas / Nederland
Pays-Bas / Nederland
 Nordique / Nordic
Nordique / Nordic
 Pologne / Polska
Pologne / Polska
 Portugal / Portugal
Portugal / Portugal
 Roumanie & Moldavie / România & Moldova
Roumanie & Moldavie / România & Moldova
 Slovénie / Slovenija
Slovénie / Slovenija
 Serbie et Monténégro / Србија и Црна Гора
Serbie et Monténégro / Србија и Црна Гора
 Espagne / España
Espagne / España
 Suisse / Schweiz
Suisse / Schweiz
 Turquie / Türkiye
Turquie / Türkiye
 Royaume-Uni et Irlande / UK & Ireland
Royaume-Uni et Irlande / UK & Ireland
 International / International
International / International
 Brésil / Brasil
Brésil / Brasil
 Canada / Canada
Canada / Canada
 Amérique latine / Latinoamérica
Amérique latine / Latinoamérica
 États-Unis / USA
États-Unis / USA
 Chine / 中国
Chine / 中国
 Inde / भारत गणराज्य
Inde / भारत गणराज्य
 Pakistan / Pākistān
Pakistan / Pākistān
 Vietnam / Việt Nam
Vietnam / Việt Nam
 ANASE / ASEAN
ANASE / ASEAN
 Israël / מְדִינַת יִשְׂרָאֵל
Israël / מְדִינַת יִשְׂרָאֵל
 Algérie, Maroc et Tunisie / الجزائر والمغرب وتونس
Algérie, Maroc et Tunisie / الجزائر والمغرب وتونس
 Moyen-Orient / Middle East
Moyen-Orient / Middle East

To post a reply please login or register